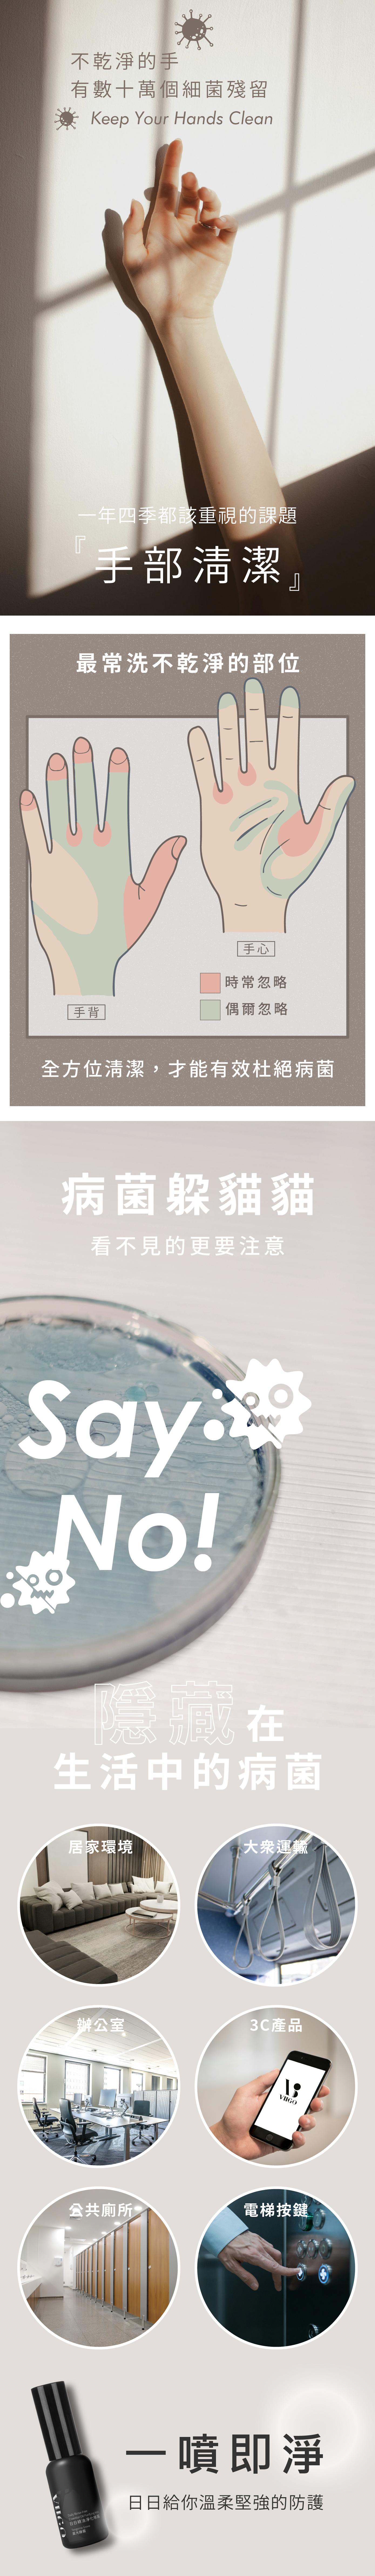

{{ 'fb_in_app_browser_popup.desc' | translate }} {{ 'fb_in_app_browser_popup.copy_link' | translate }}
{{ 'in_app_browser_popup.desc' | translate }}
擊退負能量給你溫柔堅強的防護
調和五行香氛精油
『能量、療癒、靜心、撫慰、無畏』
萃取多種大自然的植物、花、葉、樹木及果實
淨化混沌的雜訊
達到能量平衡的舒適狀態
「晨光靜霧」
置身在陽光幽然林間
霧氣混雜甜橙與草香
隨著香氣沉浸在精油與芬多精的多重饗宴
小巧瓶身小廢包攜帶超方便
商品存貨不足,未能加入購物車
您所填寫的商品數量超過庫存
{{'products.quick_cart.out_of_number_hint'| translate}}
{{'product.preorder_limit.hint'| translate}}
每筆訂單限購 {{ product.max_order_quantity }} 件
現庫存只剩下 {{ quantityOfStock }} 件